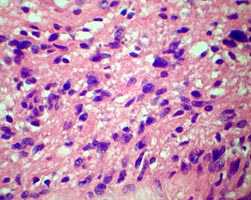
Микропрепарат параганглиомы

УЗ-признаки параганглиомы каротидного тельца
Добавил пользователь Дмитрий К. Обновлено: 21.11.2025
Параганглиомы головы и шеи или опухоли гломуса - это нейроэндокринные опухоли, источником которых являются параганглионарные клетки, мигрировавшие в период внутриутробного развития из нервного гребня и находящиеся в близких взаимоотношениях с ганглионарными клетками вегетативной нервной системы.
Их можно подразделить на 2 группы: симпатические и парасимпатические. Ранее они описывались как хемодектомы, или опухоли гломуса, однако термин «параганглиома» является более предпочтительным. В настоящее время параганглиомы классифицируются согласно их анатомической локализации, например, каротидная параганглиома, югулярная параганглиома, вагальная параганглиома и так далее.
В области головы и шеи параганглиомы, как правило, исходят из каротидного тельца, тимпанического сплетения, яремной луковицы, вагальных и симпатических ганглиев. Наиболее частым местом локализации параганглиом на голове и шее является бифуркация общей сонной артерии.
Каротидные параганглиомы обычно представляют собой опухолевидное образование в области шеи. Обычно параганглиомы характеризуются медленным ростом и бессимптомным течением, что является одной из причин их поздней диагностики (чаще после 50 лет).
Увеличиваясь в размерах, опухоль может распространяться вдоль сонных артерий с вовлечением в патологический процесс расположенных рядом нервов, включая блуждающий, подъязычный нервы, симпатический ствол. Именно с этим связана клиническая симптоматика заболевания: головные боли, боли в области шеи, головокружение, осиплость голоса, першение в горле, дисфагия, синдром Горнера-Клода Бернара, нарушение слуха.
Клиническое наблюдение

Рис. 1. Дуплексное сканирование сонных артерий.
Пациент Т., 36 лет, поступил в отделение сосудистой хирургии НМХЦ им. Н.И. Пирогова в июне 2007 г. с жалобами на наличие опухолевидного образования в левой половине шеи, дисфагию. Данное образование отмечалось у пациента в течение нескольких лет, при этом за последние несколько месяцев отмечено увеличение опухоли в размерах.
При физикальном обследовании определялось опухолевидное образование размером 6х4 см, с гладкой поверхностью, плотно-эластической консистенции, безболезненное, малоподвижное. По данным ультразвукового дуплексного сканирования внечерепных отделов брахиоцефальных артерий в левой подчелюстной области было выявлено округлое образование, в капсуле, размерами 62х41х37 мм, со слабой васкуляризацией по стенкам и в центре опухоли, не связанное с сонными артериями.
Образование принадлежит к латеральной стенке левой каротидной бифуркации и передне-латеральной стенке проксимальной порции левой внутренней сонной артерии. Также отмечалась С-образная извитость левой внутренней сонной артерии, вызванная механическим сдавлением объёмным образованием (рис.1).
При компьютерной томографии было подтверждено наличие объемного образования с участками повышенной (54 ед.) и пониженной (30 ед.) плотности (рис. 2). Образование раздвигает окружающие ткани и оттесняет левую подчелюстную слюнную железу кпереди.

Рис. 2. Компьютерная томография мягких тканей шеи
С целью уточнения особенностей кровоснабжения опухоли, а также решения вопроса о возможной эмболизации питающих опухоль сосудов была выполнена ангиография дуги аорты и брахиоцефальных артерий. При ангиографическом исследовании было выявлено слабо васкуляризованное образование, вызывающее перегиб левой внутренней сонной артерии в первом сегменте (рис.3).
Учитывая отсутствие крупных питающих опухоль сосудов, селективная эмболизация не выполнялась.


Рис. 3. Ангиография дуги аорты и брахиоцефальных артерий
Учитывая, что по данным литературы консервативное лечение параганглиом шеи неэффективно, пациенту была выполнена радикальная операция: удаление опухоли средней трети шеи слева.
Техника операции
В условиях общей анестезии был выполнен разрез по переднему краю грудинно-ключично-сосцевидной мышцы. Выделены и взяты на держалки общая, внутренняя и наружная сонные артерии.
Обнажены подъязычный и блуждающий нервы. При ревизии было установлено, что опухоль исходит из симпатического ствола и тесно связана с последним (рис. 4 А, Б).
После этого образование было выделено и удалено в пределах здоровых тканей с резекцией симпатического ствола. Опухоль имела хорошо выраженную капсулу и макроскопически напоминала невриному (рис. 5.). Следует отметить, что в до- и интраоперационном периоде проводилось определение толерантности больного к пережатию сонной артерии: транскраниальная допплерография, измерение ретроградного давления в общей сонной артерии.

Рис.4. А. Интраоперационная картина.
Б. Схема расположения опухоли.


Рис. 5. Макропрепарат параганглиомы
При гистологическом исследовании опухоль была представлена вытянутыми веретеновидными клетками с обилием разнокалиберных сосудов.
При этом обращали на себя внимание гиперхромия и полиморфизм опухолевых клеток (рис. 6 А, Б). Таким образом, был подтвержден диагноз атипичной параганглиомы.

Рис. 6. А и Б. Микропрепарат параганглиомы
Послеоперационный период протекал без осложнений, и пациент был выписан на седьмые сутки после операции. К настоящему времени срок наблюдения за пациентом составляет более двух лет.
Рецидивирования симптоматики и опухолевого роста у пациента не отмечено.
© 2022 ФГБУ «НМХЦ им. Н.И. Пирогова» Минздрава России. Использование материалов сайта полностью или частично без письменного разрешения строго запрещено.
Каротидная хемодектома
Каротидная хемодектома - опухоль из ткани каротидного гломуса, располагающегося в области бифуркации сонной артерии. Чаще протекает доброкачественно, реже наблюдаются инфильтративный рост и метастазирование. Характерна скудная клиническая симптоматика, единственным проявлением каротидной хемодектомы может быть наличие опухолевидного образования в области шеи. Возможны неприятные ощущения при глотании и поворотах головы, головокружение, головная боль, изменение голоса и кратковременные обморочные состояния при надавливании на опухоль. Диагноз устанавливается на основании жалоб, данных осмотра, результатов УЗИ, КТ, МРТ и других исследований. Лечение оперативное.
Общие сведения
Каротидная хемодектома - новообразование, происходящее из нейроэндокринных клеток, локализующееся на боковой поверхности шеи, в области деления общей сонной артерии. Относится к группе опухолей АПУД-системы. Диагностируется редко. Признаки малигнизации, по различным данным, выявляются в 6-25% случаев. Отмечается отсутствие корреляции между морфологической структурой клеток каротидной хемодектомы и ее клиническими проявлениями. Возможно благоприятное течение при наличии гистологических признаков злокачественности. В качестве основного критерия малигнизации рассматривают особенности симптоматики (быстрый рост, рецидивирование и метастазирование).
Причины развития каротидной хемодектомы неизвестны. Патология может возникать в любом возрасте, однако чаще поражает пациентов 20-60 лет. Преобладают больные женского пола. Обычно опухоль обнаруживается с одной стороны, реже бывает двухсторонней. Заболевание может выявляться у близких родственников. Для доброкачественных каротидных хемодектом характерно медленное прогрессирование, описаны случаи, когда подобные опухоли существовали в течение 30 и более лет. При озлокачествлении прогноз неопределенный - одни пациенты живут годами и даже десятилетиями, другие погибают через несколько лет от множественных метастазов. Лечение осуществляют специалисты в области онкологии, сосудистой хирургии и нейрохирургии.
Патологическая анатомия каротидной хемодектомы
Каротидная хемодектома представляет собой рыхлое и мягкое, реже плотное круглое или овальное опухолевидное образование размером от 0,5 до 5 и более сантиметров. Происходит из каротидной железы (сонного гломуса) - параганглия, клетки которого предположительно участвуют в регуляции кровяного давления и углеводного обмена. Располагается в области бифуркации сонной артерии. Различают четыре варианта взаимоотношений между сонной артерией и каротидной хемодектомой: опухоль локализуется между внутренней и наружной ветвями сонной артерии; окружает внутреннюю ветвь сонной артерии; окружает наружную ветвь сонной артерии; охватывает зону бифуркации и обе ветви сонной артерии.
Каротидная хемодектома часто «раздвигает» ветви сонной артерии, увеличивая угол бифуркации. Наблюдается инфильтрация адвентиция прилегающей части сосуда, что затрудняет оперативное отделение опухоли и существенно повышает риск хирургического вмешательства. Каротидная хемодектома плотно прилегает к подъязычному, языкоглоточному и блуждающему нерву, однако прорастание параневрия отсутствует. Опухоли большого размера распространяются в зачелюстное пространство. Гигантские новообразования могут подниматься до основания черепа и спускаться в средостение.
Злокачественные каротидные хемодектомы врастают в мышечную ткань стенки сонной артерии. Со временем сосуд теряет эластичность и превращается в жесткую трубку. Возможно прорастание близлежащих анатомических структур, метастазирование в кости, регионарные лимфатические узлы и отдаленные органы. При прогрессировании процесса образуется конгломерат, включающий в себя прилегающие нервы, внутреннюю яремную вену, глотку и грудино-ключично-сосцевидную мышцу. Цвет доброкачественных каротидных хемодектом на разрезе розовато-коричневый, злокачественных - с сероватым оттенком. В процессе микроскопического исследования обнаруживаются крупные округлые или полигональные клетки. Клетки соединяются в клубочки, лежащие в строме. При малигнизации выявляется клеточная атипия.
Симптомы каротидной хемодектомы
У трех из четырех пациентов болезнь годами протекает бессимптомно или малосимптомно. Поводом для обращения к онкологу становится обнаружение опухолевидного образования на боковой поверхности шеи или увеличение размера давно существующей опухоли. Реже больные с каротидной хемодектомой предъявляют жалобы на неприятные ощущения при глотании или поворотах головы, болезненность при надавливании, боли, иррадиирующие в голову, лицо и ухо. Могут наблюдаться головные боли и головокружения, обусловленные уменьшением просвета сонной артерии. При росте каротидной хемодектомы возникают прогрессирующие неврологические нарушения из-за сдавления близлежащих нервов.
У некоторых пациентов в анамнезе выявляются падения артериального давления и кратковременные обморочные состояния при надавливании на опухоль. Возможны осиплость голоса, внезапные приступы слабости, урежение ЧСС и лабильность артериального давления. Иногда у больных с каротидной хемодектомой развиваются психические расстройства по типу онкофобии. При пальпации определяется мягкое или плотное опухолевидное образование, обычно расположенное выше угла нижней челюсти. Верхний полюс узла может не прощупываться. Из-за тесной связи с сонной артерией может возникать ощущение пульсации опухоли.
Диагностика каротидной хемодектомы
Диагноз устанавливается на основании анамнеза, жалоб, данных внешнего осмотра и результатов инструментальных исследований. Больных с подозрением на каротидную хемодектому направляют на ультразвуковое дуплексное сканирование сосудов, позволяющее оценить структуру, размер и степень васкуляризации новообразования, а также определить особенности расположения опухоли по отношению к бифуркации и ветвям сонной артерии. Мультиспиральная КТ информативна при определении взаимоотношений между каротидной хемодектомой и соседними анатомическими структурами, может использоваться для проведения дифференциальной диагностики с некоторыми другими заболеваниями.
МРТ с контрастированием позволяет получить информацию о расположении и структуре каротидной хемодектомы, ее связи с близлежащими органами и состоянии регионарных лимфатических узлов. На заключительном этапе назначают селективную каротидную ангиографию для определения особенностей кровоснабжения новообразования. При необходимости эта процедура также может использоваться в лечебных целях - для эмболизации сосудов, питающих каротидную хемодектому. Окончательный диагноз выставляют с учетом результатов цитологического исследования образца тканей, полученного в процессе пункционной биопсии.
Дифференциальную диагностику каротидной хемодектомы осуществляют с новообразованиями щитовидной железы, слюнных желез, нервов, фасций, мышц и подкожной жировой клетчатки, с аневризмой сонной артерии, с неспецифическим лимфаденитом при хронических заболеваниях полости рта и ЛОР-органов, со специфическим лимфаденитом при туберкулезе и сифилисе, а также с метастатическим поражением лимфатических узлов шеи.
Лечение каротидной хемодектомы
Лечебную тактику определяют в зависимости от особенностей клинического течения болезни. При отсутствии быстрого роста и признаков злокачественности хирургическое вмешательство не показано даже при наличии значительного косметического дефекта, поскольку из-за тесной связи каротидной хемодектомы с крупными сосудами любая операция сопряжена с высоким риском для пациента. При компрессии органов шеи и хронических нарушениях мозгового кровообращения, обусловленных давлением на артерии и изменением положения ветвей сонной артерии, выполняют удаление новообразования. Сосуды сохраняют, аккуратно выделяя их из опухолевой массы.
В случае, когда выделение сосуда затруднено, производят перевязку наружной сонной артерии. При тесной спаянности доброкачественной каротидной хемодектомы с сонной артерией возможно частичное вылущивание опухоли с сохранением части капсулы, прилегающей к сосудам. При злокачественном процессе осуществляют удаление опухоли, резекцию бифуркации и ветвей сонной артерии и замещение пораженных сосудов трансплантатом. При доброкачественных новообразованиях близлежащие нервы, как правило, удается сохранить. При злокачественных каротидных хемодектомах нервы иссекают вместе с измененными тканями.
Чтобы иметь возможность контролировать кровоснабжение головного мозга, хирургические вмешательства обычно выполняют под местной анестезией. При крупных новообразованиях используют интубационный наркоз. Учитывая риск развития массивного кровотечения, операции проводят после подготовки достаточного количества крови, кровезаменителей и противошоковых препаратов. Радиотерапия и химиотерапия при лечении каротидных хемодектом не используются из-за неэффективности.
Прогноз при доброкачественных новообразованиях зависит от распространенности опухоли, ее связи с близлежащими анатомическими структурами и ряда других факторов. Злокачественные каротидные хемодектомы рассматриваются, как прогностически неблагоприятные. Продолжительность жизни определяется степенью агрессивности местного роста новообразования и скоростью появления отдаленных метастазов. Летальный исход может наступить в течение нескольких лет или десятилетий после постановки диагноза.
Параганглиомы
В практике применения ГН имеют значение яремная и тимпаническая гломусные опухоли.
Что такое гломусная яремная опухоль?
Некоторые авторы рассматривают гломусные опухоли как категорию, которую можно разделить на 2 подгруппы: яремные и тимпанические гломусы. Гломусные опухоли в целом являются редкими (0,6% от всех опухолей головы и шеи), однако, тимпанический гломус является самой частой опухолью среднего уха и часто пациенты обращаются с ними к отохирургам. Яремные гломусы происходят из гломусных телец, обычно в области луковицы яремной вены и распространяются вдоль сосудов. Могут иметь пальцевидные выросты в яремную вену (которые могут стать причиной эмболии во время резекции). Яремные параганглиомы очень богаты сосудами, основное кровоснабжение происходит из наружной сонной артерии с дополнительным питанием из каменистой части внутренней сонной артерии. Эти опухоли обычно содержат секреторные гранулы (даже если они являются функционально неактивными) и могут активно секретировать катехоламины, аналогично феохромоцитоме (в 1-4% случаев яремных гломусов). В функционально активных опухолях будет повышен норэпинефрин, т.к. им не хватает метилтрансферазы для превращения его в эпинефрин. Напротив, могут выделяться серотинин и калликреин, что может вызывать карциноид-подобный синдром (сужение бронхов, гипертония, гепатомегалия и гипергликемия).
Какие симптомы могут соответствовать параганглиоме?
Обычно клинические проявления выражаются в потере слуха и пульсирующем звоне в ухе. Третьим по частоте симптомом является головокружение. Также возможна боль в ухе. Потеря слуха может носить кондуктивный (напр., из-за закупорки слухового канала) или нейросенсорный характер (из-за внедрения в лабиринт), что часто сопровождается головокружениеями (наиболее часто вовлекаемым черепно-мозговым нервом является VIII). Встречаются различные сочетания поражений IX, X, XI и XII ЧМН, иногда бывает паралич VII нерва (обычно за счет вовлечения в канале лицевого нерва в пирамиде височной кости). При обширных поражениях, которые вызывают сдавление ствола мозга, могут быть атаксия и/или гидроцефалия. Иногда симптомы могут быть обусловлены выделением продуктов секреции опухоли, что может проявляться гиперадреналовыми кризами, бронхоспазмами и другими симптомами.
Какие методы диагностики применяются при подозрении на параганглиому?
Отоскопическое исследование может выявить пульсирующую красно-синюю массу за барабанной перепонкой, при тимпаническом характере опухоли (иногда ЛОР-врачи, к сожалению, пунктируют ее для биопсии, что может привести к массивному кровотечению).
Эндокринные исследования. Для определения секреции катехоламинов в суточном анализе мочи определяют ванил-манделиевую кислоту, метанефрины и общий уровень катехоламинов.
Компьютерная томография используется для того, чтобы определить расположение и распространенность опухоли. Спиральная КТ в костном режиме с тонкими срезами (0.5-1 мм) лучше помогает оценить литическое действие опухоли на костные структуры основания черепа в виде расширения яремного отверстия, барабанной полости и др. СКТ в режиме перфузии выявляет объемное образование со скоростью кровотока близкой к таковому в яремной вене, что помогает дифференцировать параганглиому от других видов опухолей данной локализации.
Магнитно-резонансная томография без контраста и с контрастом, в т.ч. с подавлением сигнала от жировой ткани, помогает определить не только внутричерепной рост, но и внечерепное распространение в мягкие ткани шеи по ходы сосудисто-нервного пучка.
Ангиография выявляет выраженную сосудистую сеть опухоли, что помогает исключить, например, невриному слухового нерва; позволяет оценить состояние противоположной яремной вены на тот случай, если при операции придется пересекать яремную вену на стороне поражения; обычно луковица яремной вены и/или сама вена частично или полностью окклюзированы. Проведение ангиографии оправдано в случае подготовки к операции, для одномоментного проведения эндоваскулярной эмболизации.
Какие методы лечения параганглиом наиболее эффективны?
Медикаментозное лечение параганглиом, активно продуцирующих катехоламины, консервативное лечение является эффективной паллиативной мерой, а также вспомогательным методом при подготовке к проведению эмболизации или хирургического вмешательства. Назначение альфа- и бета-блокаторов перед эмболизацией или операцией позволяет предотвратить угрожающие жизни больных колебания АД и аритмии.
Лучевая терапия в настоящее время, утратила свое значение ввиду невысокой эффективности и выраженных побочных эффектов. В целом, может ослабить симптомы и замедлить рост опухоли. При очень больших опухолях, или при невозможности хирургии или радиохирургии, рекомендуются стереотаксическое облучение в дозе 40-45 Гр в виде сеансов по 2 Гр, либо ≈35 Гр в виде 15 сеансов по 2,35 Гр, что также показало свою эффективность, но при этом было меньше побочных эффектов. В качестве основного метода лечения параганглиомы обычно используется только при больших опухолях. В последнее время накапливается опыт гипофракционированной радиотерапии, об эффективности и отдаленных результатах которой судить еще рано
Эндоваскулярная эмболизация обычно используется при больших опухолях, при благоприятных вариантах кровоснабжения (напр., при наличии сосудов, которые можно эмболизировать селективно без угрозы попадания эмболов в нормальный мозг), однако имеет свои особенности:
- постэмболизационный отек опухоли может приводить к увеличению давления на ствол мозга или мозжечек
- при эмболизации активно секретирующих опухолей требуется осторожность, т.к. в результате инфаркта опухоли возможен выброс вазоактивных веществ (напр., эпинефрина)
- у больных, которым нельзя осуществить хирургическое лечение, ее можно использовать в качестве основного лечения. Но в этом случае эмболизация будет только временной паллиативной мерой, т.к. через какое-то время кровоснабжение опухоли восстанавливается и рост продолжается.
Хирургическое лечение. При небольших опухолях, располагающихся только в среднем ухе, хирургическая резекция является несложным, эффективным методом лечения, выполняемом отохирургами. Роль хирургического лечения при больших опухолях, которые внедряются в кость и разрушают ее, не определена. В этих случаях проведение операции чревато множественными параличами черепно-мозговых нервов, а также связано с возможностью возникновения опасного кровотечения, что обычно приводит к частичной резекции. Рекомендуется проведение операции группой хирургов, состоящей из нейрохирурга, отохирурга, а также специалиста по хирургии головы и шеи. При этом используется подход к основанию черепа через шею. Сначала перевязывают питающие сосуды из системы наружной сонной артерии, а затем быстро дренажные вены (для того, чтобы предотвратить системное действие выделяющихся катехоламинов). Пересечение яремной вены переносится нормально, если противоположная вена проходима. Даже после проведения тотальной резекции рецидивы могут быть ≈ в ⅓ случаев.
Наиболее частыми осложнениями являются образование ликворной фистулы в основании черепа, нарушения мимики, дизартрия и дисфагия различной степени в результате нарушения функций черепно-мозговых нервов (VII-XII). Значительная кровопотеря сопровождает практически все операции по удалению яремных параганглиом, что требует серьезной предварительной подготовки со стороны нейроанестезиологов и нейрореаниматологов. Во время хирургического вмешательства на этих опухолях может происходить также выброс гистамина и брадикинина, что вызывает гипотонию и бронхоспазм, что также требует предварительной предоперационной подготовки и своевременных действий во время операции.
Радиохирургия. Применение Гамма-ножа является высокоэффективным методом лечения небольших яремных и тимпанических параганглиом. Безрецидивная 5-летняя и 10-летняя выживаемость составляют 96 и 91%, соответственно. Дисфункция 7 чмн встречается примерно в 0.5-1% случаев, снижение слуха после радиохирургии - 1.2-1.5%, дисфункция каудальных нервов с развитием дизартрии и\или дисфагии
Каротидная хемодектома — это новообразование, произрастающее из ткани каротидного синуса (нейроэндокринная ткань АПУД-системы). Локализуется в области передней поверхности шеи — там, где происходит бифуркация сонной артерии.
Каротидное тельце — это образование размером в несколько миллиметров. С точки зрения функциональности, оно является хеморецептором и реагирует на уровень кислорода, СО2, рН и глюкозы в крови. При изменении этих показателей, оно направляет сигналы в центральную нервную систему, которая должна дать соответствующий регуляторный ответ.
Чаще всего хемодектома доброкачественная, но есть случаи инфильтративного роста и метастазирования. При доброкачественном течении она растет медленно, годами. Но образование может малигнизироваться. По разным данным это происходит у 6-25% пациентов. Прогноз здесь непонятный — некоторые люди живут десятилетиями, а другие погибают за несколько лет.
Причины возникновения
В целом, в зависимости от причин развития выделяют три вида опухолей:
- Спорадические — возникают случайно, в основном регистрируются у пациентов в возрасте 20-60 лет, женщины болеют чаще.
- Семейный — встречается у близких родственников, чаще обнаруживается у лиц молодого возраста.
- Гиперпластический тип — ключевым фактором развития здесь выступает хроническая гипоксия (например, проживание в условиях высокогорья, хронические заболевания легких и др.).
Виды хемодектом
В зависимости от гистологического строения, выделяют следующие виды опухолей:
- Ангиоматозная.
- Альвеолярная.
- Смешанная.
- Атипичная.
По типу взаимодействия с окружающими тканями выделяют:
- Неинвазивную хемодектому — она не прорастает в окружающие ткани, хотя может плотно прилегать к ним и приводить к компрессии.
- Локальноинвазивные — опухоль затрагивает окружающие ткани, прорастая, например, в наружную оболочку сонной артерии. Этот факт еще не свидетельствует о злокачественности хемодектомы.
- Инвазивная — помимо инвазии в окружающие ткани, опухоль дает метастазы. Это уже злокачественный вариант.
В зависимости от особенностей расположения выделяют следующие виды хемодектом:
- Малая опухоль или первый тип — новообразование располагается между двумя ветвями сонной артерии, тесно соприкасаясь с ее стенками, но не инфильтрируя их. Диаметр опухоли не превышает 2,5 см.
- Хемодектома 2 степени. Имеет размеры от 2,5 до 5 см, плотно спаяна с адвентицией (наружной оболочкой) сонной артерии.
- Хемодектома 3 степени — опухоль более 5 см, окружает обе ветви сонной артерии и прорастает сосудистую стенку до интимы.
Симптомы хемодектомы
Хемодектома имеет вид округлой или овальной опухоли размером 0,5-5 см. При пальпации чаще всего она имеет плотную консистенцию, но может отмечаться и рыхлость. Локализуется она в переднем треугольнике шеи, под грудинно-ключично-сосцевидной мышцей, там, где сонная артерия делится на две ветви. При пальпации опухоль смещается в горизонтальном направлении, но не в вертикальном. Также ощущается пульсация, которая идет от сонной артерии.
Три четверти пациентов не предъявляют каких-либо жалоб на свое состояние. К врачу они обращаются из-за того, что их беспокоит сам факт наличия опухоли, или если она начинает увеличиваться в размерах. Реже могут быть жалобы на болезненность при надавливании на новообразование, неприятные ощущения при поворотах головы или глотании. По мере увеличения хемодектомы присоединяются неврологические нарушения, возникающие из-за компрессии нервов: осиплость голоса, нарушение глотания (поперхивание). При нарушении регуляторной функции возникают приступы слабости, брадикардия (уменьшение частоты сердцебиений), скачки давления.
Диагностика
В рамках диагностики проводится внешний осмотр, собирается анамнез, уточняется время появления новообразования, его увеличение, определяется наличие жалоб. Далее пациенту назначаются инструментальные методы исследования:
- УЗИ с дуплексным сканированием сосудов — позволяет визуализировать саму опухоль, определить ее взаимоотношение с сонной артерией и особенности собственного кровоснабжения.
- КТ и МРТ с контрастированием — определяют взаимоотношение хемодектомы с окружающими тканями, вовлечение в процесс кровеносных сосудов и нервов, состояние регионарных лимфатических узлов и возможные метастазы.
- Селективная каротидная ангиография. С помощью этого исследования определяют особенности кровоснабжения хемодектомы и ее взаимоотношения с сонной артерией. Новообразование питается от ветвей этой артерии, образуя обильную сеть сосудов.
Обычно этих данных хватает для постановки диагноза. Что касается морфологического подтверждения, то биопсию выполнять не рекомендуют, поскольку она может спровоцировать серьезное кровотечение.
Лечение
Единственным методом радикального решения проблемы является хирургическое удаление опухоли. Если есть данные за злокачественный процесс, ее дополняют лучевой терапией. Схема лечения определяется индивидуально в зависимости от следующих факторов:
- Особенности расположения хемодектомы и ее взаимодействие с окружающими тканями. Например, опухолевые клетки могут инфильтрировать оболочки сосуда или плотно прилегать к крупным нервам, находящимся в области шеи. Если опухоль имеет большие размеры, она может прорастать в зачелюстное пространство, средостение или подниматься до основания черепа. Злокачественные хемодектомы прорастают в окружающие ткани и образуют обширные конгломераты, охватывающие крупные нервы, сосуды, мышцы и даже кости.
- Размеры новообразования.
- Наличие клинической симптоматики.
- Наличие метастазов.
Если опухоль доброкачественная и не вызывает симптомов, ее не рекомендуют удалять, даже если она имеет большие размеры и вызывает эстетический дефект. Все дело в том, что лечение сопряжено с высокими рисками — во время операции можно повредить сосуды, питающие головной мозг, и нервные стволы, отвечающие за важные функции. Облучение при доброкачественной хемодектоме будет неэффективно, кроме того, после него будет еще сложнее провести операцию, поскольку есть высокая вероятность образования постлучевого фиброза.
Операция при хемодектоме является технически сложным хирургическим вмешательством и требует особых навыков у хирургической бригады, а также высокотехнологичного оснащения операционной. Выполнять ее рекомендуется в крупных онкологических центрах, которые специализируются на опухолях головы и шеи. Сеть федеральных клиник экспертной онкологии Евроонко как раз является таким учреждением. У нас работают высококвалифицированные врачи, а также имеется все необходимое оборудование для проведения операций такого уровня сложности.
Прогноз при хемодектоме
Что касается прогноза, то однозначного ответа здесь дать невозможно. Доброкачественные опухоли протекают десятилетиями и могут вообще никак не беспокоить пациента. В 9-10% случаев они могут трансформироваться в рак, но даже здесь могут быть варианты. Некоторые пациенты с единичными метастазами живут и десятилетиями, а другие погибают через несколько лет.
В нашей клинике занимаются лечением данного заболевания опытные врачи в соответствии с современными протоколами. Это позволяет в каждом случае достигать максимально возможного результата.
Параганглиома среднего уха ( Гломангиома среднего уха , Гломусная опухоль среднего уха , Нехромаффиннная параганглиома среднего уха , Хемодектома среднего уха )
Параганглиома среднего уха - это доброкачественная опухоль, сформированная из нехромаффинных параганглиев, расположенная на медиальной стенке барабанной полости. К основным клиническим проявлениям заболевания относятся снижение слуха, пульсирующий шум в ушах, неврологическая симптоматика. Высокой информативностью в диагностике параганглиомы обладают микроотоскопия, рентген и компьютерная томография височной кости, магнитно-резонансная томография. Основное лечение включает проведение хирургического вмешательства, лучевой терапии. В случаях, когда операция не показана, могут быть назначены симптоматические средства (НПВС, анальгетики).
МКБ-10
Параганглиома (гломусная опухоль, нехромаффиннная параганглиома, хемодектома, гломангиома) среднего уха - одна из доброкачественных опухолей головы и шеи, поражающая преимущественно барабанную полость, сосуды, нервы. Впервые была описана в 1941 году американским профессором анатомии С. Гилдом. Гломусная опухоль встречается с частотой 1:300000, является одним из самых распространённых доброкачественных образований среднего уха. Известно, что женщины болеют в 5-7 раз чаще мужчин. Основные симптомы заболевания манифестируют в возрасте 55-60 лет, у детей и подростков такая патология обнаруживается крайне редко.
Причины
В настоящее время причины развития гломангиомы достоверно неизвестны. Выявлено, что она может возникать спонтанно под действием внешних воздействий среды на организм человека или же наследоваться по аутосомно-доминантному типу от родителей. За развитие наследственных форм болезни отвечают мутации генов, участвующих в кодировании B, C, D ферментно-митохондриального комплекса сукцинат-дегидрогеназы. Опухоль может входить в структуру генетических заболеваний (синдром МЭН 2А типа, болезнь Гиппеля-Линдау).
Спорадическая хемодекома формируется у людей в возрасте 40-50 лет. На её развитие могут оказывать влияние инфекционные заболевания, бесконтрольный приём стероидов и гормональных контрацептивов, аутоиммунные болезни. Также причиной возникновения образования из параганглиев могут стать любые состояния, приводящие к изменению работы эндокринной системы. К ним относят беременность, патологии яичников, щитовидной железы.
Патогенез
Параганглиома образуется из гломусных телец, которые располагаются во внешней оболочке луковицы яремной вены, в области мыса, по ходу ветвей языкоглоточного, блуждающего нерва, а также в пирамиде височной кости. Эти клетки представляют собой хеморецепторы и реагируют на различные стимулы путем синтеза гормонов. При развитии опухолевого перерождения клеток образование биологически активных веществ происходит постоянно.
Элементы АПУД-системы могут продуцировать катехоламины и пептидные гормоны. В процессе роста доброкачественное образование проникает в барабанную полость, заполняет её, постепенно нарушая целостность барабанной перепонки, повреждая прилежащие сосуды и нервы. По мере разрастания гломусная опухоль может выступать в наружный слуховой проход.
При гистологическом исследовании выявляются крупные округлые клетки с явлениями секреторной активности (образование в цитоплазме вакуолей, наличие в ней гранул). Клетки опухоли формируют клубочки, вдающиеся в просвет сосудов. Соединительная ткань параганглиомы представлена коллагеновыми волокнами, синусоидными капиллярами. Участки между клетками заполнены мелкозернистым веществом, образующим гомогенную массу.
Симптомы
У большинства пациентов с параганглиомой среднего уха клиническая картина развивается постепенно и связана с повреждением внутричерепных нервов. Больные жалуются на снижение остроты слуха, периодически возникающий звон в ушах. Он имеет пульсирующий характер, может усиливаться при наклонах вниз или резких движениях головой. Эти симптомы связаны не только с разрушением лабиринта, но и с компрессией улиточной части преддверно-улиткового нерва.
Если опухоль выходит в просвет слухового прохода, она часто травмируется, что сопровождается незначительными кровянистыми выделениями, которые остаются на подушке и волосах после сна. В некоторых случаях пациенты жалуются на периодическое повышение артериального давления. Это напрямую связано с избыточным образованием биологических веществ, увеличивающих тонус сосудов.
Общая неврологическая симптоматика при гломусном новообразовании характеризуется развитием постоянных головных болей диффузного характера, слабостью, усталостью. Наблюдается снижение работоспособности, ухудшается память и концентрация. При поражении преддверной части VIII черепного нерва страдает вестибулярный аппарат. Развивается нистагм, могут возникать головокружения и обморочные состояния.
Осложнения
Без лечения гломангиома прогрессирует, что способствует потере слуха, развитию псевдобульбарного синдрома, неврита лицевого нерва. Это может привести к тяжёлым неврологическим расстройствам. Находящееся в просвете слухового прохода образование легко травмируется, в области повреждения может возникнуть инфекция. При нарушении целостности сосудов гломусной опухоли возникает внутреннее кровотечение в полость черепа. В редких случаях (менее 5%) происходит перерождение доброкачественной опухоли в злокачественную с последующим метастазированием.
Диагноз параганглиомы среднего уха ставится на основании жалоб больного, данных осмотра врача-отоларинголога, инструментальных и лабораторных исследований. В рамках диагностических мероприятий показана консультация невролога. К основным методикам, применяемым для верификации диагноза, относят:
- Физикальное обследование. При осмотре в наружном слуховом проходе обнаруживается образование, напоминающее полип, которое обладает контактной кровоточивостью. Показательным является положительный симптом пульсации при введении воронки в слуховой проход. Использование микроотоскопии позволяет выявить контуры параганглиомы в виде бордового пятна за барабанной перепонкой.
- Неврологические исследования. Для определения характера поражения нервов используется электронейромиография: она регистрирует снижение скорости проведения нервных импульсов. Функцию вестибулярного аппарата оценивают с помощью обертовой пробы, пробы Ромберга.
- Исследование функции органов слуха. С этой целью проводятся камертональные пробы. Чаще выявляется нейросенсорная тугоухость, связанная с повреждением слухового нерва. Аудиометрия позволяет оценить остроту слуха, снижающуюся при развитии доброкачественной хемодектомы.
- Генетическое обследование. У всех пациентов с параганглиомой обязательно собирается семейный анамнез, чтобы установить наследственную предрасположенность и составить родословную. Полимеразная цепная реакция с ДНК пациента обнаруживает мутации в геноме, отвечающие за развитие опухолевого процесса.
- Лабораторные исследования. Биохимическое исследование крови и мочи позволяет оценить уровень метаболитов катехоламинов. Их повышение указывает на избыточное образование этих биологических веществ и является косвенным доказательством наличия нехромаффинного образования.
- Инструментальные исследования. Чтобы определить характер поражения, размеры и локализацию патологического образования, используют рентгенографию, КТ височной кости. Магнитно-резонансное исследование позволяет определить степень повреждения венозных и артериальных сосудов головы . Ангиография используется непосредственно перед оперативным вмешательством и выявляет источники кровоснабжения гломангиомы.
Дифференциальный диагноз параганглиомы на начальной стадии проводится с отосклерозом, аневризмой сонной артерии, средним отитом. При повреждении нервов патологию необходимо дифференцировать с параличом гортани, гемангиомой, невритом лицевого нерва. Реже дифдиагностика осуществляется с невриномой преддверно-улиткового нерва, холестеатомой среднего уха, черепно-мозговой травмой.
Лечение параганглиомы среднего уха
Хирургическое лечение хемодектомы проводится в отделении отоларингологии. Больному необходимо соблюдать палатный режим, а также придерживаться диеты с большим содержанием белков, витаминных и минеральных комплексов. К основным методам лечения относятся:
- Лучевая терапия. Использование гамма-ножа, кибер-ножа, линейного и протонного ускорителя позволяет удалить опухолевые клетки и предотвратить дальнейший рост образования. Радиохирургия может быть использована в качестве дополнения к хирургическому лечению или в форме монотерапии у пожилых пациентов.
- Хирургическое вмешательство. Операция проводится как традиционным открытым методом, так и с помощью эндоскопического оборудования. Перед ней осуществляется эмболизация источников кровоснабжения опухоли, способствующая деваскуляризации патологического образования. Гломангиома полностью или частично удаляется вместе с изменёнными тканями, восстанавливается целостность височной кости. При необходимости осуществляется реконструкция барабанной перепонки.
- Симптоматическая терапия. При неоперабельной параганглиоме с целью облегчения общего состояния пациентам назначают анальгетики, нестероидные противовоспалительные препараты. Для компенсации тугоухости используются классические слуховые аппараты.
Прогноз и профилактика
При своевременном удалении параганглиомы среднего уха прогноз для жизни и здоровья пациента благоприятный. Уже в первую неделю после оперативного вмешательства наблюдается исчезновение основных симптомов, нормализуется слух. При необоснованном отказе от хирургического лечения существует вероятность развития опасных для пациента осложнений. Профилактика развития параганглиомы сводится к проведению генетического исследования у людей, входящих в группу высокого риска, а также к защите организма от неблагоприятных воздействий внешней среды в течение жизни.
1. Хирургическое лечение параганглиом пирамиды височной кости/ Гуляев Д.А., Чеботарев С.Я., Яковенко И.В.// Креативная хирургия и онкология. - 2011.
2. О диагностике и тактике лечения гломусных опухолей с интракраниальным ростом/ Мустафин Х.А., Смагулов Ф.Х., Бердиходжаев М.С., Шпеков А.С., Толбаева Г.К., Сыздыкбаева Ш.М.// Нейрохирургия и неврология Казахстана. - 2012.
3. Гломусная опухоль (параганглиома) уха. Современное состояние проблемы. Литературный обзор/ Аникин И.А. , Комаров М.В.// Российская оториноларингология - 2010 - № 4.
Читайте также:
- Правый желудочек при легочном сердце. Гипертрофия правого желудочка с блокадой ножки пучка Гиса
- Методика организации и проведения групповой терапии в психотерапии
- УЗИ переферических сосудов брюшной полости. УЗИ сосудов аорты.
- Значение нарушений вестибуло-вегетативных рефлексов. Трудности оценки вестибуло-вегетативных рефлексов
- УЗИ, МРТ при аденомиоме матки
